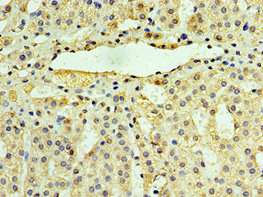

-
中文名稱:UCHL3兔多克隆抗體
-
貨號:CSB-PA025543DSR2HU
-
規格:¥440
-
圖片:
-
其他:
產品詳情
-
產品名稱:Rabbit anti-Homo sapiens (Human) UCHL3 Polyclonal antibody
-
Uniprot No.:
-
基因名:UCHL3
-
別名:Ubiquitin carboxyl-terminal hydrolase isozyme L3 antibody; Ubiquitin thioesterase L3 antibody; Ubiquitin thiolesterase antibody; Ubiquitin thiolesterase L3 antibody; UCH L3 antibody; UCH-L3 antibody; UCHL3 antibody; UCHL3_HUMAN antibody
-
宿主:Rabbit
-
反應種屬:Human
-
免疫原:Recombinant Human Ubiquitin carboxyl-terminal hydrolase isozyme L3 protein (1-220AA)
-
免疫原種屬:Homo sapiens (Human)
-
標記方式:Non-conjugated
-
克隆類型:Polyclonal
-
抗體亞型:IgG
-
純化方式:Antigen Affinity Purified
-
濃度:It differs from different batches. Please contact us to confirm it.
-
保存緩沖液:PBS with 0.02% sodium azide, 50% glycerol, pH7.3.
-
產品提供形式:Liquid
-
應用范圍:ELISA, IHC
-
推薦稀釋比:
Application Recommended Dilution IHC 1:20-1:200 -
Protocols:
-
儲存條件:Upon receipt, store at -20°C or -80°C. Avoid repeated freeze.
-
貨期:Basically, we can dispatch the products out in 1-3 working days after receiving your orders. Delivery time maybe differs from different purchasing way or location, please kindly consult your local distributors for specific delivery time.
-
用途:For Research Use Only. Not for use in diagnostic or therapeutic procedures.
相關產品
靶點詳情
-
功能:Deubiquitinating enzyme (DUB) that controls levels of cellular ubiquitin through processing of ubiquitin precursors and ubiquitinated proteins. Thiol protease that recognizes and hydrolyzes a peptide bond at the C-terminal glycine of either ubiquitin or NEDD8. Has a 10-fold preference for Arg and Lys at position P3'', and exhibits a preference towards 'Lys-48'-linked ubiquitin chains. Deubiquitinates ENAC in apical compartments, thereby regulating apical membrane recycling. Indirectly increases the phosphorylation of IGFIR, AKT and FOXO1 and promotes insulin-signaling and insulin-induced adipogenesis. Required for stress-response retinal, skeletal muscle and germ cell maintenance. May be involved in working memory. Can hydrolyze UBB(+1), a mutated form of ubiquitin which is not effectively degraded by the proteasome and is associated with neurogenerative disorders.
-
基因功能參考文獻:
- The authors find that UCHL3 regulates COPS5-dependent deneddylation of Cullin1, which is an essential component of SCF(beta-TrCP) complex and associated with SCF(beta-TrCP) activities. The authors further demonstrate that UCHL3 upregulates the levels of SCF(beta-TrCP) substrates including IFN-I receptor IFNAR1, which enhances IFN-I mediated signaling pathway and antiviral activity. PMID: 28583475
- Study demonstrated positive correlations between the level and activity of UCHL3 and sperm characteristics and function suggesting that UCHL3 may play a role in male infertility. PMID: 27780264
- Using a series of engineered protein substrates, which are similar in size yet differ in secondary structure, we demonstrate that thermal stability is a key factor that significantly affects UCH-L3 hydrolysis. PMID: 25369561
- UCH-L3 is a novel regulator of epithelial-mesenchymal transition and cell migration in prostate cancer cells. PMID: 25194810
- Data identified of UCHL3 as an essential deubiquitinase in adipogenesis. PMID: 22679485
- impaired UCH-L3 function may contribute to the accumulation of full length UBB(+1) in various pathologie PMID: 21762696
- 1.45 A resolution crystal structure of human UCH-L3 in complex with the inhibitor ubiquitin vinylmethylester, an inhibitor that forms a covalent adduct with the active site cysteine of ubiquitin-specific proteases PMID: 15531586
- Upregulation of UCH-L3 is associated with Uterine Cervical Neoplasms PMID: 16402389
- Substrate filtering by the active site crossover loop in UCHL3 revealed by sortagging and gain-of-function mutations. PMID: 19047059
- These results indicate that mono-Ub and Ub dimers may regulate the enzymatic functions of UCH-L1 and UCH-L3, respectively, in vivo. PMID: 19154770
- Untangling the folding mechanism of the 5(2)-knotted protein UCH-L3 PMID: 19476499
- identification and the sequence-specific assignments for 186 out of the 218 UCH-L3 (230 less 12 prolines) backbone 15N and amide proton resonances PMID: 19636824
顯示更多
收起更多
-
亞細胞定位:Cytoplasm.
-
蛋白家族:Peptidase C12 family
-
組織特異性:Highly expressed in heart, skeletal muscle, and testis.
-
數據庫鏈接:
Most popular with customers
-
-
YWHAB Recombinant Monoclonal Antibody
Applications: ELISA, WB, IHC, IF, FC
Species Reactivity: Human, Mouse, Rat
-
Phospho-YAP1 (S127) Recombinant Monoclonal Antibody
Applications: ELISA, WB, IHC
Species Reactivity: Human
-
-
-
-
-